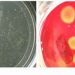
सेल्युलोज – टाकाऊ पदार्थापासून कार्बन विलग करणारा जिवाणू

प्रतिनिधी / पुणे
कृषी आयुक्तालयात कृषी आयुक्त धीरजकुमार यांच्या हस्ते अॅग्रोवर्ल्ड फार्मच्या जानेवारी महिन्याच्या विशेषांकाचे प्रकाशन करण्यात आले. सोबत अॅग्रोवर्ल्ड फार्मचे संपादक शैलेंद्र चव्हाण, पश्चिम महाराष्ट्र प्रतिनिधी वंदना कोर्टीकर. श्री धीरजकुमार यांनी अॅग्रोवर्ल्ड फार्ममध्ये प्रसिद्ध करण्यात आलेल्या प्रक्रिया उद्योगाच्या यशोगाथांचे अवलोकन करून अंकातील विषय तसेच अंकाच्या दर्जाबाबत समाधान व्यक्त केले. दुसऱ्या छायाचित्रात कृषी व निविष्ठा गुणवत्ता संचालक दिलीप झेंडे अॅग्रोवर्ल्ड फार्मच्या जानेवारी महिन्याच्या विशेषांकाचे प्रकाशन करतांना. अॅग्रोवर्ल्ड फार्मचे संपादक शैलेंद्र चव्हाण यावेळी उपस्थित होते.